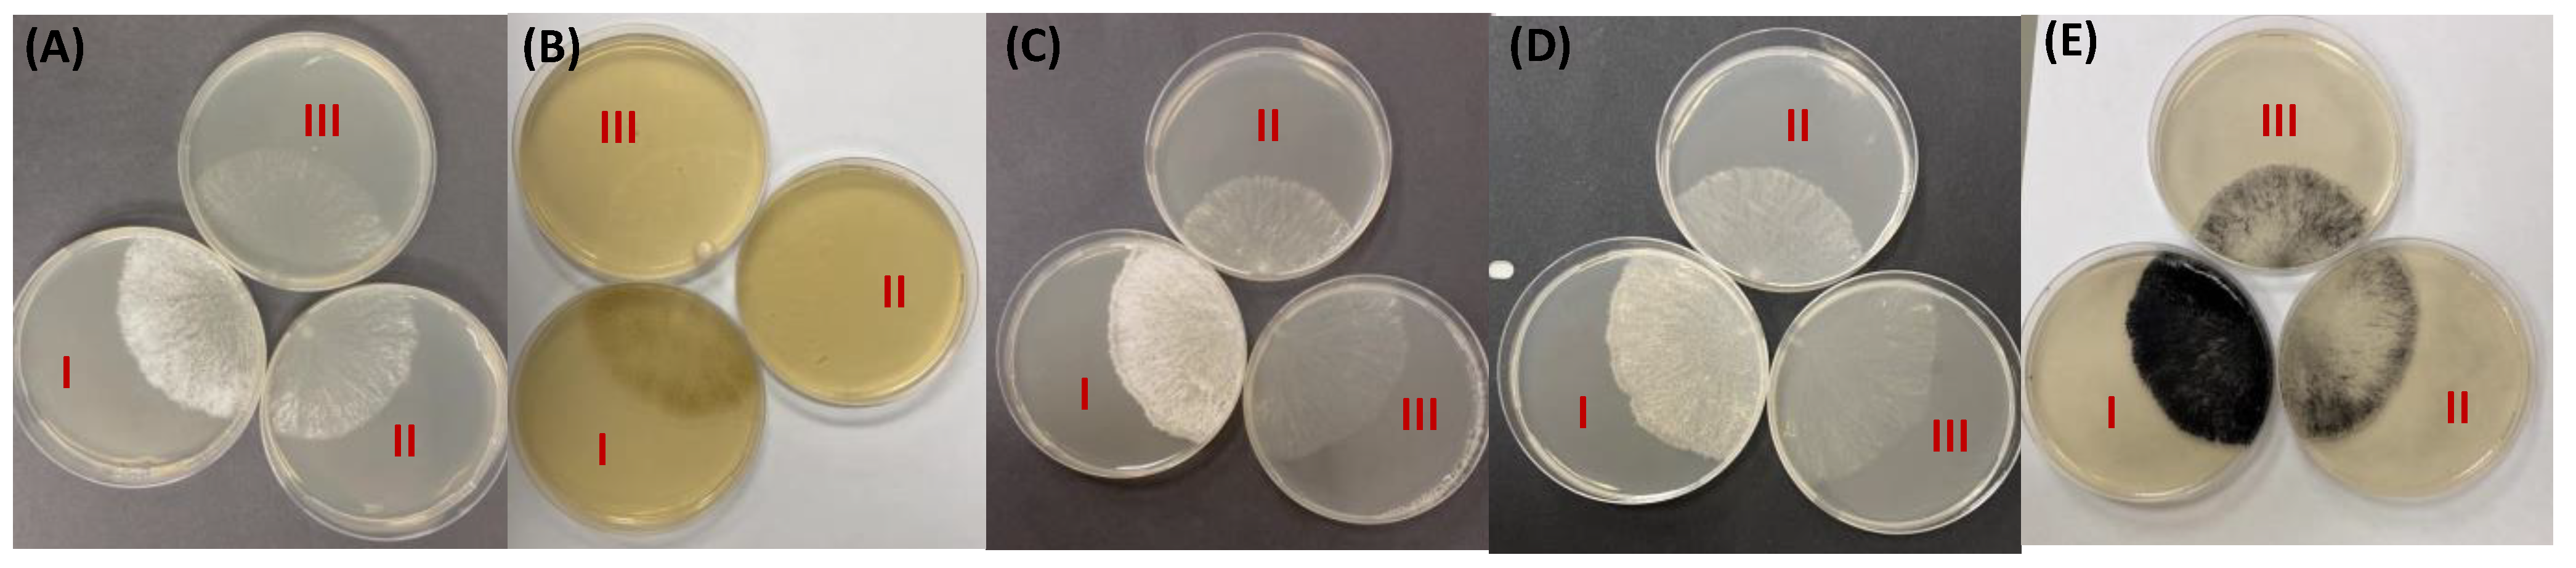
Microorganisms 12 01509 g004

1. Introduction
The fungal cell wall is a dynamic organelle which protects the cell from environment stress and allows the cell to interact with the environment. The cell wall is largely composed of glucans and glycoproteins. A variety of glucans have been observed in cell walls. Chitins, β-1,3-glucans, mixed β-1,3/1,4-glucans, and α-1,3-glucans have been shown to be cross-linked together to create a cell wall polysaccharide matrix. In filamentous fungi, galactosaminogalactans (GAGs) have also been shown to be cell wall elements. GAGs are long polymers of α-1,4-linked galactose, galactosamine, and
N-acetylgalactosamine residues which are thought to adopt an elongated, nearly straight confirmation with the amino groups (
N-acetylgalactosamine and galactosamine) pointing to the solvent and available for binding partners [
1,
2]. In
N. crassa, GAGs were observed in the growth medium by Reissig and Glasgow [
3], and a GAG deacetylase was briefly studied by Jorge et al. [
4]. The enzymes for the GAG biosynthetic pathway are encoded in a five-gene cluster in a variety of ascomycete genomes [
5]. These enzymes include a GAG synthase, a UDP-glucose 4 epimerase (to convert UDP-glucose and UDP-
N-acetylglucosamine to UDP-galactose and UDP
N-acetylgalactosamine), a GH135 family GAG hydrolase (a spherulin 4-like hydrolase called sph3), a GH114 family galactosaminidase, and an
N-acetylgalactosamine deacetylase.
The literature shows that the GAG from the Aspergilli is a heteropolymer containing galactose, galactosamine, and
N-acetylgalactosamine residues [
2]. The
Aspergillus fumigatus GAG is initially synthesized with acetylated galactosamines, and the deacetylase then partially deacetylases the GAG to create a polycationic polymer. In
A. fumigatus, GAG is essential for various pathogenic processes such as virulence, biofilm formation, antibiotic resistance, immune modulation and evasion, adhesion to host cells, adhesion to plastics, and adhesion to negatively charged surfaces [
5,
6,
7,
8,
9,
10,
11,
12]. GAG has been shown to mask the β-1,3-glucan elements in the cell wall to shield them from the host immune system [
9,
13]. GAGs have also been shown to be required for cell-to-cell adhesions and aggregation of
Aspergillus oryzae [
14,
15]. In the insect pathogenic fungus
Metarhizium robertsii, a GAG has also been found to function as an adhesive to the insect cuticle and to be needed for biofilm formation [
16].
Since GAG biosynthetic clusters are common in the ascomycetes [
5,
6], including many fungi that are nonpathogenic fungi (saprophytes) and plant pathogens, the question of what advantages GAGs offer to these fungi remains to be determined. In our studies on the
N. crassa cell wall, we noticed that one of our major cell wall proteins, NCW-1 (NCU05137) [
17,
18,
19], is a homolog of the
A, fumigatus GAG deacetylase Agd-1. The
A. fumigatus deacetylated GAG was shown to be required for biofilm formation and for the hyphae to adhere to each other [
5,
7,
14,
15]. To better characterize the
N. crassa cell wall and ask what advantages a GAG might offer to saprophytes and plant pathogens, we characterized the
N. crassa GAG biosynthetic pathway. Characterization of the polysaccharides from the growth medium provided evidence of the GAG synthase functioning to produce a polysaccharide containing galactosamine and
N-acetylgalactosamine. We found that the loss of the GAG synthase affected the tensile strength of the fungal mycelia and its ability to adhere to a glass surface, alumina, cellite, activated charcoal, and wheat grass. The
N. crassa GAG hydrolase (NCU05136) was found to have hydrolytic activity towards a polysaccharide found in the growth medium. We found evidence suggesting that both the acetylated and deacetylated forms of GAGs are polysaccharide adhesins. In our studies, we found that the deacetylated GAG produced by wild-type hyphae mediates adhesion to glass surfaces and provides the fungal network tensile strength, suggesting that the deacetylated GAG facilitates intercellular interactions within the hyphal network. We found that the acetylated GAG produced by the deacetylase mutant mediated adhesion to chitin, alumina, celite (diatomaceous earth), wheat grass, and activated charcoal particulates. We believe that the acetylated GAG and chitin are both synthesized near the edge of the growing colony and the ability of the acetylated GAG to adhere to chitin may facilitate adherence of the GAG to the cell wall. We hypothesize that the ability of the acetylated GAG to adhere to wheat grass particulates and similar plant-derived material could facilitate the digestion of such materials by saprophytes and plant pathogens. The ability of the acetylated GAG to bind to activated charcoal (burnt plant material) is especially interesting for
N. crassa, which grows prolifically on burnt trees following forest fires. We propose that the acetylated GAG may facilitate the adhesion of the fungus to natural substrates such as burnt wood and leaf debris present in the soil.
2. Materials and Methods
2.1. Strains and Growth Conditions
N. crassa strains were obtained from the Fungal Genetics Stock Center. The mutant strains used were from the Neurospora deletion library [
20]. A listing of the strains is provided in
Table 1. The strains were routinely cultured on Vogel’s sucrose minimal medium [
21]. Homokarytic deletion mutant isolates for NCU05132, NCU05135, and NCU05137 were available from the deletion library. To verify that the deletion mutants from the library contained the specified deletions, primers for amplifying the 5′ end of the normal and deletion mutant genes were generated for NCU05132, NCU5136, and NCU5137 (
Table 2). Small-scale DNA preparations from the deletion mutants were prepared and used for PCR reactions. PCR reactions with the gene-specific forward primer (labelled XF) and a hygromycin-specific reverse primer (HygroR) were used to amplify the deletion mutant gene and PCR reactions with the gene-specific forward and reverse primers (labelled XF and XR) were used to amplify the normal gene (
Table 2). Analysis of the ∆NCU05132 and ∆NCU05137 demonstrated that these deletion mutants contained the correct deletions (
Figure S1). The NCU05136 deletion mutant was found as a heterokaryon (isolate with both wild-type and deletion mutant nuclei) in the deletion library. PCR analysis of the genomic DNA from hygromycin-resistant progeny from the heterokaryon showed that the NCU05136 gene was not deleted, and the mutant was not further characterized.
2.2. Cloning HIS6-Tagged NCU05136
An HIS6-tagged version of the GAG hydrolase (NCU05136) coding region was generated, purified, and used to examine its enzymatic activities. Primers 5136F and 5136H6R were used to PCR-amplify the GAG hydrolase coding region with the HIS6 tag located at the carboxyl terminus (
Table 2). The PCR product was purified by electrophoresis in an agarose gel, isolated using a QIAquick gel extraction kit (Qiagen, Hilden, Germany), and cloned into the pJET vector (Thermo Scientific, Carlsbad, CA, USA). The cloned genes were then subcloned into a pMF272 vector [
22] that had been digested with BamHI and EcoRI to create the p5136H6 plasmid. The plasmid contained a portion of the
his-3 coding region, the
ccg-1/grg-1 promoter, the cloned coding regions for NCU05136, and the 3′ utr from the
his-3 gene. The
his-3 coding region and 3′utr allowed for insertion of plasmid DNA sequences into the
N. crassa genome in the 3′utr region of the
his-3 gene by homologous recombination [
22]. Insertion of the plasmid into the
his-3 locus of an
his-3 mutant generated a histidine auxotroph and allowed for the easy isolation of transformants. The
ccg-1/grg-1 promoter allowed for high-level expression of the tagged GAG hydrolase [
23]. The p5136H6 plasmid was used in transformation experiments to generate
N. crassa strains expressing the H6-tagged GAG hydrolase.
2.3. Purification of the H6-Tagged GAG Hydrolase (NCU05136)
Transformant strains expressing the GAG hydrolase were grown at 30 °C for 48 h at room temperature in a liquid Vogel’s 2% sucrose medium in a shaker incubator (120 rpm). The cells were harvested on a Buchner funnel, ground to a fine powder under liquid nitrogen with a mortar and pestle, and suspended in 5 mL 10 mM imidazole, 50 mM NaPO4, and 300 mm NaCl. Following a centrifugation step (12,000× g for 10 min), the supernatant was loaded onto a 1 mL nickel Probond column (ThermoFischer, Waltham, MA, USA), and the column was washed with 25 mL of the suspension buffer. The column was then washed with 10 mL of 25 mM imidazole, 50 mM NaPO4, and 300 mm NaCl. The GAG hydrolase was eluted with a liner gradient of imidazole (25 mM to 250 mM) in 50 mM NaPO4, and 300 mm NaCl, and the factions containing the purified protein were identified by Coomassie stained PAGE and by Western blot analysis. The purification steps on the Probond column were carried out at 4 °C.
2.4. Assays Testing Adhesive Properties of Hyphal Networks
To assess whether a particulate could adhere to hyphae, wild-type and mutant isolates were inoculated at the edge of a Petri dish containing Vogel’s sucrose agar medium and allowed to grow at 30 °C for between 16 and 20 h. Alumina, activated charcoal, and celite particulates were suspended in distilled water at a concentration of 10 mg/mL, and 10 mls was added to the Petri dish and allowed to sit for 30 min. The plate was then gently swirled, and the liquid, with any loose particulates, was poured off. The plates were then washed seven times by gently adding 10 mL of water, gently swirling, and dumping the water with any loose particulates. The plates were then allowed to dry for about 30 min and photographed. Adhesion of wheat grass to the hyphae was assessed in the same manner, except that the initial concentration of wheat grass was 3 mg/mL. Alumina was obtained from Sorbtech (Norcross, GA, USA). Celite and activated charcoal were obtained from Sigma-Aldrich (St. Louis, MO, USA). Wheat grass was obtained from Pines International, Inc. (Lawrence, KS, USA).
To determine if the presence of the GAG affected the tensile strength of a hyphal mat, wild-type and mutant strains were grown at 30 °C for 5 days in 25 mL of liquid Vogel’s sucrose in a 125 Erlenmeyer flask with an aluminum foil cap. The hyphal mats, which formed on the surface of the medium, were collected on a Buchner funnel and blotted dry. The hyphal mats were folded twice to give a thickness four times that of the original mat and placed in a penetrometer apparatus (
Figure S2), and the tensile strength of the hyphal mat was determined. The penetrometer (model FT 02) was purchased from QA Supplies (Norfolk, VA, USA). The home-made apparatus was constructed from 2 sheets of plexiglass with an array of nine 3 mm holes drilled into the plexiglass sheets. A 2 mm probe was used in the penetrometer for measuring hyphal tensile strength.
A centrifugation assay was used to examine the ability of hyphae to bind to a glass surface. Wild-type and mutant hyphae were grown in 5 mL of Vogel’s sucrose medium in a 30 mL Corex centrifuge tube for 3 days at 30 °C in a slant rack and then the Corex tube was placed in an upright position for another 24 h to allow hyphae the grow up the sides of the Corex tube. The tubes were then photographed for a “pre-centrifugation” image. The tubes were carefully filled with water to near the top and centrifuged at 2500× g for 5 min in a swinging bucket rotor. After centrifugation, the water was carefully aspirated from the centrifuge tubes and the tubes were photographed for a “post-centrifugation” image. The ability of the hyphae to adhere to the glass Corex tube was determined by examining the sides of the centrifuge tubes for the presence of hyphae.
2.5. Assays for GAG Hydrolase Activity by TLC (Thin-Layer Chromatography) and PACE (Polysaccharide Analysis Using Carbohydrate Gel Electrophoresis)
Substrates for a GAG hydrolase assay are not commercially available, so we used polysaccharides collected from the growth media in which wild-type and mutant cells had grown as substrates for our assays. To test for GH114-1 hydrolase activity, we incubated our purified H6-tagged GH114-1 hydrolase (NCU05136) with polysaccharides from the wild type. The polysaccharides were obtained by growing the strains in 400 mL of liquid Vogel’s 2% sucrose medium at 30 °C for 3 days in a shaker incubator and collecting the growth medium in a Buchner funnel. Ethanol was added to a final concentration of 70%, and the polysaccharides were allowed to precipitate at 4 °C for 2 days. The precipitated polysaccharides were collected by centrifugation (8000×
g for 10 min) and washed with 70% ethanol. The precipitated polysaccharides were then resuspended in 800 µL water. The assay for GAG hydrolase included 5 µL of purified GH114-1, 22 µL of polysaccharide and 3 µL of 1 M sodium acetate pH 5.0 buffer. The hydrolase and polysaccharides were incubated at room temperature for 24 h, and the hydrolysis of GAG was assessed by thin-layer chromatography (TLC) and PACE gel electrophoresis. For TLC analysis, the sample was spotted onto a TLC plate (TLC silica gel 60 from Merck, Darmstadt, Germany), and chromatography was performed with a (5:2:3) mixture of N-butanol:acetic acid:water solvent for 3.5 h. The TLC plates were then stained by spraying with orcinol reagent (1% orcinol in 70:3 mixture of ethanol:sulfuric acid) and heating to 100 °C for 15 min. For PACE analysis, the digested polysaccharides were labelled at their reducing ends with ANTS (8-aminonaphthalene-1,3,6-trisulfonic acid) and subjected to electrophoresis in a 15% polyacrylamide gel as described by Pidatala et al. [
24].
2.6. Compositional Analysis of Dried Polysaccharides from the Growth Medium via Methanolysis and TMS Derivatization
To determine if polysaccharides from the growth medium contained galactose and
N-acetylgalactosamine, a carbohydrate composition determination was carried out on the polysaccharides released by wild-type, ∆NCU05132 (GAG synthase) and ∆NCU05137 (GAG deacetylase) cells grown in 100 mL of Vogel’s sucrose liquid medium in a shaker incubator (120 rpm) at 30 °C for three days. Polysaccharides were collected from the growth medium with a 70% ethanol precipitation, washed with a 70% ethanol wash, air-dried, and subjected to a carbohydrate compositional analysis. Glycosyl composition analysis was performed by combined gas chromatography–mass spectrometry (GC-MS) of the per-O-trimethylsilyl (TMS) derivatives of the monosaccharide methyl glycosides produced from the sample by acidic methanolysis as described previously by Coleman et al. [
25]. Briefly, 200–400 mg dried samples were heated with 1 M methanolic HCl in a sealed screw-top glass test tube for 18 h at 80 °C. After cooling and removal of the solvent under a stream of nitrogen, the samples were re-N-acetylated by treatment with acetic anhydride and pyridine in methanol and dried again. The samples were then derivatized with Tri-Sil
® (Thermo) at 80 °C for 30 min. GC-MS analysis of the TMS methyl glycosides was performed on an Agilent 7890A GC interfaced to a 5975C MSD, using a Supelco Equity-1 fused silica capillary column (30 m, 0.25 mm ID) with a temperature gradient.
2.7. Compositional Analysis of Concentrated Polysaccharide via Nitrous Acid Digestion and Generation of Alditol Acetates
Because a large amount of medium polysaccharide was not soluble following ethanol precipitation or drying, we also obtained medium polysaccharide samples via an evaporation protocol. Growth media from the wild type, GAG synthase mutant, and GAG deacetylase mutant were collected on a Buchner funnel, and 100 mL of medium was evaporated down to a volume of 5 mL in a speed vac. The samples were then dialyzed against water and further concentrated to 2 mL in the speed vac. An analysis of the galactosamine and N-acetylated galactosamine within the polysaccharides was determined by employing nitrous acid conversion of the galactosamine to 2,5 anhydrotalose and then generation of alditol acetates from all of the sugar residues in the samples [
26]. Briefly, 100 µL of the concentrated polysaccharide samples were combined with 100 µL 0.3 M nitrous acid solution (492 µL nonpure water, 16 µL acetic acid, 269 mg sodium nitrite). The solutions were allowed to react at room temperature for 50 min. Next, 250 µL of a sodium carbonate solution (100 mg/mL in water) was added to neutralize, and the samples were reduced by addition of 250 µL sodium borohydride solution (60 mg/mL in water). Reduction was carried out overnight at room temperature. The samples were then neutralized by addition of 100 µL acetic acid and dried under nitrogen to remove the nitrous acid and acetic acid. Finally, the samples were lyophilized to dryness. To separate the carbohydrate from contaminating salt, the samples were acetylated by addition of 500 µL each of pyridine and acetic anhydride to the dried samples. The samples were heated to 100 °C for 1 h. The acetylated carbohydrates were then extracted using a mixture of equal parts water and dichloromethane. The dichloromethane layer was washed 5 times with fresh water to remove all the salt. Finally, the dichloromethane layer containing the acetylated sample was transferred to a fresh tube and dried. Alditol acetates were then prepared from the samples via hydrolysis in trifluoroacetic acid (400 µL, 2 M TFA, 120 °C, 2 h), reduction with sodium borodeuteride (300 µL of a 10 mg/mL solution in water, 4 h at room temperature), and re-acetylation (250 µL of both pyridine and acetic anhydride, 100 °C, 1 h). The derivatized samples were again extracted using dichloromethane, and the resultant alditol acetates were run on an Agilent 7890A GC interfaced to a 5975C MSD (mass selective detector, electron impact ionization mode); separation was performed on a Supelco Equity-1 fused silica capillary column (30 m × 0.25 mm ID). Alongside the samples, a standard containing glucose, galactose, mannose, galactosamine, and N-acetyl galactosamine was run. To the samples and standard, ribose was added as an internal standard.
4. Discussion
GAGs are long linear α-1,4-linked polysaccharides containing galactose, galactosamine, and
N-acetylgalactosamine residues [
1,
2]. They have been shown to play important roles in cell-to-cell interactions, the formation of biofilms, and in human and insect pathogenesis [
5,
6,
7,
8,
9,
11,
12,
16]. A cluster of five genes involved in the synthesis of GAGs has been shown to be present in a large variety of ascomycetes (
Figure 1) [
5]. The five gene cluster contains the following: (1) a UDP-glucose 4-epimase to convert UDP-glucose and UDP-
N-acetylglucosamine to UDP-galactose and UDP-
N-acetylgalactosamine, which are needed for the synthesis of the polysaccharide, (2) a GAG synthase which generates an acetylated GAG, (3) a GAG deacetylase which partially deacetylates the GAG to produce a polycationic polysaccharide, (4) a GH135 GAG hydrolase (sph3 spherulin 4-like protein) which is needed for GAG synthesis and is able to hydrolyze acetylated GAGs, and (5) a GH114 endo-α-1,4-galactosaminidase able to cleave deacetylated GAG. While GAG synthesis and function have been extensively studied in the human pathogen
A. fumigatus, the role of the GAG pathway has not been carefully examined in saprophytic fungi and fungal plant pathogens. While
N. crassa is generally considered to be a saprophyte, it is closely related to several plant pathogens and has been shown to be a pathogen in conifers [
31]. We have examined the role of the pathway in
N. crassa by characterizing the polysaccharides produced by mutants affected in the pathway and by characterizing the phenotypic consequences of losing pathway enzymes.
GAG was first identified in
N. crassa by Reissig and Glasgow [
3] and the GAG deacetylase has been partially purified and characterized [
4]. However, the composition and structure of the GAGs were not elucidated in these early studies. Work in
A. fumigatus demonstrated that GAG is a heteropolymer containing galactose,
N-acetylgalactosamine and galactosamine and that the deacetylase was needed for the synthesis of what was thought to be the functional product of the pathway, a partially deacetylated GAG [
2,
6,
7].
The activity of EGA3, the
A. fumigatus homolog of
N. crassa GH114-1 endo-α-1,4-galactosaminidase, has been previously examined [
30]. Bamford et al. determined the crystal structure of the protein, identified the active site and a number of important interactions involved in its enzymatic activity, and demonstrated that it was an endo-α-1,4-galactosaminidase able to recognize deacetylated GAG [
30]. The
N. crassa enzyme is encoded by NCU05136 and, like the enzymes encoded in other fungal genomes, the encoded sequence includes a transmembrane domain (amino acids 39 to 62). We cloned the NCU05136 gene, expressed a His6-tagged version of the protein in
N. crassa, and purified the protein. We examined the enzymatic activity of the purified enzyme and were able to demonstrate with a TLC analysis and a PACE gel analysis that the enzyme cleaves a polysaccharide found in the growth medium from wild-type cells. We concluded that NCU05136 has enzymatic activity. The major digestion product identified in the TLC analysis and PACE gel analysis have an apparent size of an oligosaccharide with 4 or 5 sugar residues, indicating that the enzyme is an endo glycosylhydrolase. We found that the purified enzyme did not have activity on p-nitrophenyl-α-D-galactopyranoside, consistent with the enzyme functioning as an endo hydrolase. Without a highly purified substrate, we were unable to further characterize the enzyme, but our observations are consistent with the enzyme serving as an endo-α-1,4-galactosaminidase capable of digesting a GAG.
We showed that the deletion mutant for the deacetylase produced some extracellular polysaccharide that was soluble after ethanol precipitation containing galactosamine and/or
N-acetylgalactosamine residues (
Table 3). The soluble polysaccharides from the wild type lacked galactosamine and/or
N-acetylgalactosamine residues. The results showed there are differences between the polysaccharides produced by the wild type and mutants. We suggest that the deacetylated GAG from the wild type may remain in the insoluble polysaccharide fraction, some of the acetylated GAG from the deacetylase mutant was found among the soluble polysaccharides, and that the deacetylase is active on the GAG.
We were able to obtain compositional information about the polysaccharides in the growth medium by concentrating the growth medium via evaporation and carrying out an analysis that discriminates between galactosamine and N-acetylgalactosamine. The analysis showed that the polysaccharides from the GAG synthase contained much less galactosamine and N-acetylgalactosamine than the polysaccharides from the wild type and are consistent with the synthase producing a GAG. The analysis demonstrated that N. crassa produces multiple polysaccharides containing galactose, galactosamine, and N-acetylgalactosamine sugars. With the medium containing multiple polysaccharides, we were unable to demonstrate compositional differences between the deacetylated GAG found the medium from the wild type and the acetylated GAG found in the medium from the deacetylase mutant.
The adhesion assays comparing the adhesive properties of deacetylase mutant hyphae with the acetylated GAG and the hyphae from the wild type were informative. We found that the wild-type hyphae provided adhesion to a glass surface, while the mutant hyphae were easily dislodged from the glass surface. This is similar to the findings of others, who showed that the deacetylated GAG provided adhesion to a variety of surfaces, including plastics and insect cuticle. We also found that wild-type hyphal mats had greater tensile strength than mutant hyphal mats, suggesting that the deacetylated GAG functions to give some cell-to-cell adhesion. Deacetylated GAGs were found by others to be important for cell-to-cell adhesion (clumping in liquid medium) and biofilm formation [
5,
7,
9,
12,
14,
15]. However, we found that the acetylated GAG produced by the deletion mutant was also an adhesive. In particulate binding assays, we found that the fully acetylated GAG functioned as an adhesive to alumina, celite (diatomaceous earth), activated charcoal, and wheat grass particulates. We hypothesize that the fully acetylated GAG is produced near or at the hyphal tips located near the growing edge of a hyphal colony, where it can bind to materials such as chitin, alumina, celite, activated charcoal, and wheat grass particulates. As the colony continues to grow, the GAG is deacetylated and its adhesive properties change. The GAG becomes capable of binding other materials such as other hyphae and glass. Our observations indicate that adhesive properties of the GAG are a function of the deacetylation process and of the location of the GAG relative to the growing edge of the
N. crassa colony. This suggests a model for how GAG might be functioning within a growing fungal colony. We hypothesize that at the edge of the growing colony the newly synthesized acetylated GAG binds to newly synthesized chitin and helps anchor the GAG onto the cell wall instead of having the GAG being immediately released into the surrounding liquid. We further hypothesize that the acetylated GAG at the colony edge allows saprophytic and plant pathogenic fungi to bind to wheat grass and other similar food particulates they might find in their environment. This will facilitate the digestion of these particulates by having the particulates held tightly to the hyphae surface where the concentration of digestive hydrolases would be highest and by having their sugars and amino acids released near the plasma membrane to enhance the uptake of the nutrients. The binding of the growing edge of a hyphal colony to activated charcoal (burnt wood) by the acetylated GAG is particularly meaningful for
N. crassa, which colonizes burnt trees after a forest fire. Adhering to the surface of a burnt tree would be helpful to
N. crassa as it establishes itself in a natural environment. We hypothesize that when the acetylated GAG adheres to such particulates, it becomes protected from the deacetylase and the particulates remain adherent to the fungus. GAG not involved in such adhesions are then deacetylated to facilitate other interactions occurring farther back from the colony edge, including cell-to-cell interactions that increase the tensile strength of the hyphal network and the formation of biofilms. The GAG can be thought of as a “malleable glue” which allows the fungus to adhere to different types of surfaces and materials at different locations within a growing colony.